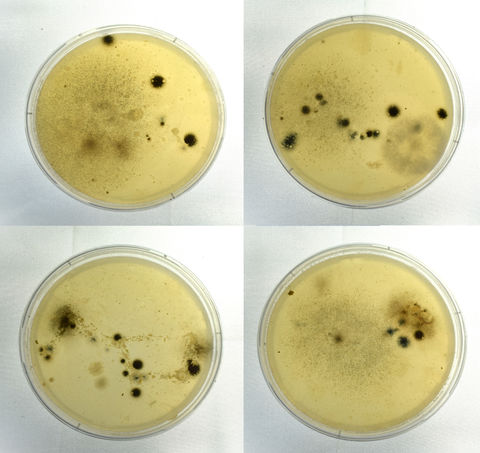
Ursa major, Petri Dishes, Varying Sizes 2024

ART MEETS SCIENCE
Giulia Mezza's works aim to integrate scientific methodologies with artistic expression.' Born into a family of educators in 1995, Giulia has always been deeply fascinated by both art and science. This dual passion led her to pursue a unique educational path, earning a Bachelor's and Master's degree in Chemistry alongside a Master's degree in Art. Her academic background fuels her creative practice: each project is approached with the precision and rigor of a researcher, blending creative exploration with the disciplined process of experimentation. In recent years, her work has evolved towards metamorphic art, where chemical reactions play a central role in transforming the artwork over time. She experiments with intelligent materials to create dynamic, responsive artworks that shift and change in reaction to environmental factors, mirroring the processes of nature and scientific discovery. Over the past decade, Giulia has exhibited her work across Italy and participated in two art residencies, engaging audiences with her innovative approach to blending art and science.
Giulia Mezza integra metodologie scientifiche ed l'espressione artistica con l'obiettivo di sviluppare una nuova branca dell'"arte scientifica". Nata nel 1995 e figlia di due insegnanti, Giulia è sempre stata profondamente affascinata sia dall'arte che dalla scienza. Questa duplice passione l'ha portata a intraprendere un percorso formativo unico, conseguendo una laurea magistrale a ciclo unico in Chimica, oltre a una laurea magistrale in Arte. Il suo background accademico alimenta la sua pratica creativa: ogni progetto è affrontato con la precisione e il rigore di una ricercatrice, fondendo l'esplorazione creativa con il disciplinato processo di sperimentazione. Negli ultimi anni, il suo lavoro si è evoluto verso l'arte metamorfica, in cui una serie di reazioni chimiche porta alla trasformazione dell'opera d'arte nel tempo. Sperimenta con materiali intelligenti creando opere d'arte dinamiche e reattive che si trasformano in risposta ai fattori ambientali. Negli ultimi dieci anni, Giulia ha esposto le sue opere in tutta Italia e partecipato a due prestigiose residenze artistiche.




Portfolio